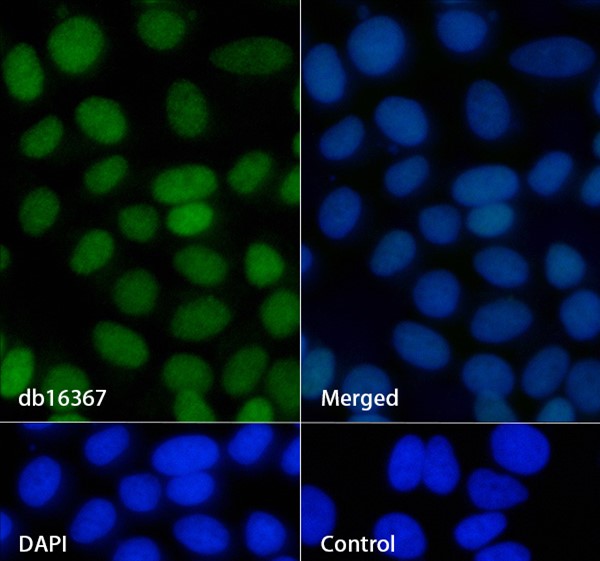

您当前的位置:
Conjugation/Formulation:Un-conjugated
- Background This gene encodes a member of a family of ubiquitously expressed heterogeneous nuclear ribonucleoproteins (hnRNPs), which are RNA-binding proteins that associate with pre-mRNAs in the nucleus and influence pre-mRNA processing, as well as other aspects of mRNA metabolism and transport. The protein encoded by this gene is one of the most abundant core proteins of hnRNP complexes and plays a key role in the regulation of alternative splicing. Mutations in this gene have been observed in individuals with amyotrophic lateral sclerosis 20. Multiple alternatively spliced transcript variants have been found. There are numerous pseudogenes of this gene distributed throughout the genome. [provided by RefSeq, Feb 2016]
- Immunogen A synthetic peptide of human hnRNP A1
-
Gene ID
3178
15382
29578
-
Swiss Prot
P09651
P49312
P04256
- Synonyms MPD3; UP 1; ALS19; ALS20; HNRPA1; IBMPFD3; HNRPA1L3; hnRNP A1; hnRNP-A1
- Reactivity Human, Mouse, Rat
- Application WB, IHC-P, ICC/IF, FC
-
Recommended dilution
WB: 1:1000-1:5000
IHC-P: 1:100
ICC/IF: 1:200
FC: 1:100 - Calculated MW 39 kDa
- Observed MW 36 kDa
- Host species Rabbit
- Clonality Monoclonal
- Clonality No. DGR36132
- Isotype IgG
- Purity Affinity Purification
- Conjugation Un-conjugated
- Storage/Stability Store at -20°C. Supplied in 50mM Tris-Glycine(pH 7.4), 0.15M NaCl, 40% Glycerol, 0.01% sodium azide and 0.05% BSA. Stable for 12 months from date of receipt.
-
 Western blot analysis of extracts from Jurkat, HepG2 cells and Rat spleen tissue using db16367 at 1:1000.
Western blot analysis of extracts from Jurkat, HepG2 cells and Rat spleen tissue using db16367 at 1:1000. -
Immunofluorescence analysis of MCF-7 cells labelling hnRNP A1 with db16367.
Immunofluorescence analysis of MCF-7 cells labelling hnRNP A1 with db16367.
The cells were fixed with 4% PFA (10min, RT) followed by treatment with 0.1% Triton X-100 (10min, RT), and blocked in 1% BSA/10% normal goat serum/0.3M glycine in 0.1% PBS-Tween 20 for 1h. The cells were then incubate with db16367 (1:200) at room temprature for 1h, followed by a further incubation at room temperature for 45min with Goat Anti Rabbit lgG (H+L)-AF488 (db10005, shown in green). Nuclear DNA was labeled in blue with DAPI.
Control: Secondary antibody only.
订购信息
- Package Price (RMB)
- 10μL 398
- 20μL 698
- 50μL 1398
- 100μL 2398
- 货期:现货
相关产品
For research use only. Not intended for diagnostic.
